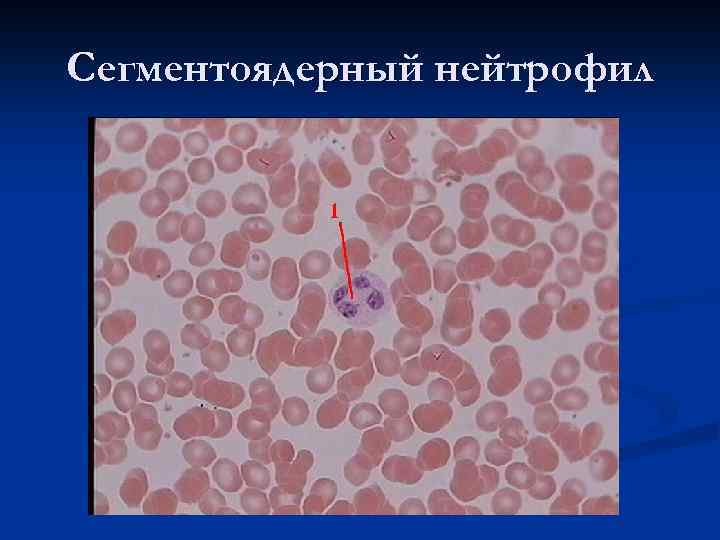
Сегментоядерный нейтрофил
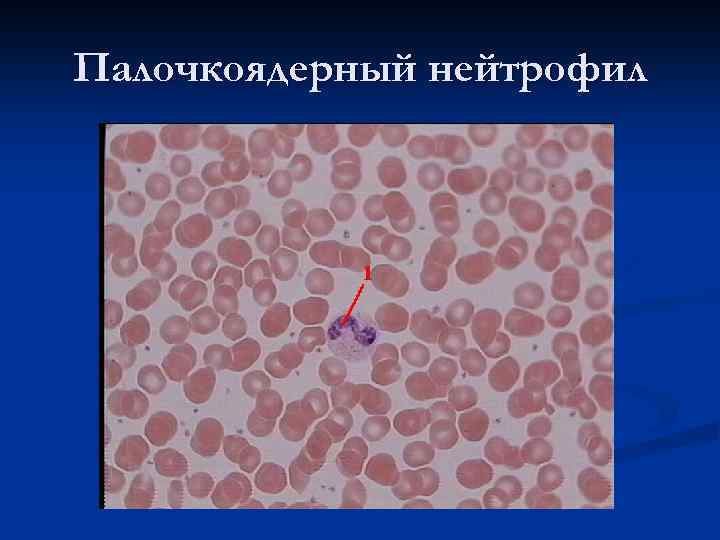
Палочкоядерный нейтрофил

Тема лекции: «Кровь и лимфа»
Тема лекции: «Кровь и лимфа»
 Состав крови: Объём крови в организме взрослого человека - около 5 л. В крови различают 2 компонента: - плазму (межклеточное вещество) - форменные элементы.
Состав крови: Объём крови в организме взрослого человека - около 5 л. В крови различают 2 компонента: - плазму (межклеточное вещество) - форменные элементы.
 Химический состав плазмы Плазма составляет 55 - 60 % объёма крови (около 3 л). Она содержит: - воду ( примерно 90 % от массы), - белки (6, 5 - 8, 5 %) - альбумины, глобулины и фибриноген, - многочисленные низкомолекулярные органические соединения - промежуточные или конечные продукты обмена веществ, переносимые из одних органов в другие; - различные неорганические ионы - в свободном состоянии или в связи со специальными транспортными белками.
Химический состав плазмы Плазма составляет 55 - 60 % объёма крови (около 3 л). Она содержит: - воду ( примерно 90 % от массы), - белки (6, 5 - 8, 5 %) - альбумины, глобулины и фибриноген, - многочисленные низкомолекулярные органические соединения - промежуточные или конечные продукты обмена веществ, переносимые из одних органов в другие; - различные неорганические ионы - в свободном состоянии или в связи со специальными транспортными белками.
 Гемограмма взрослого человека - эритроциты (красные кровяные тельца) 3, 3 – 4, 9· 10 12 1/л у женщин, 3, 5 – 5, 5 · 10 12 1/л у мужчин - лейкоциты (белые кровяные клетки) 4 - 9· 10 9 1/л, - тромбоциты (кровяные пластинки) 200 - 300· 10 9 1/л. Как видно, по сравнению с эритроцитами, лейкоцитов меньше примерно в 1000 раз, а тромбоцитов - в 20 раз.
Гемограмма взрослого человека - эритроциты (красные кровяные тельца) 3, 3 – 4, 9· 10 12 1/л у женщин, 3, 5 – 5, 5 · 10 12 1/л у мужчин - лейкоциты (белые кровяные клетки) 4 - 9· 10 9 1/л, - тромбоциты (кровяные пластинки) 200 - 300· 10 9 1/л. Как видно, по сравнению с эритроцитами, лейкоцитов меньше примерно в 1000 раз, а тромбоцитов - в 20 раз.
 Эритроцит при серповидноклеточной анемии.
Эритроцит при серповидноклеточной анемии.
 Тромбоцит 1. Несколько тромбоцитов 2. Палочкоядерный нейтрофил
Тромбоцит 1. Несколько тромбоцитов 2. Палочкоядерный нейтрофил
 Лейкоцитарная формула крови Агранулоциты, или незернистые лейкоциты Гранулоциты, или зернистые лейкоциты Нейтрофильные гранулоциты, или нейтрофилы Эозинофилы Моноциты Базофилы Лимфоциты Юные Палочкоядерные Сегментоядерные Все виды - Все виды 0 - 0, 5% 3 -5% 65 - 70 % 1 -5% 0, 5 - 1, 0 % 6 -8% 20 - 35 %
Лейкоцитарная формула крови Агранулоциты, или незернистые лейкоциты Гранулоциты, или зернистые лейкоциты Нейтрофильные гранулоциты, или нейтрофилы Эозинофилы Моноциты Базофилы Лимфоциты Юные Палочкоядерные Сегментоядерные Все виды - Все виды 0 - 0, 5% 3 -5% 65 - 70 % 1 -5% 0, 5 - 1, 0 % 6 -8% 20 - 35 %
Сегментоядерный нейтрофил
Сегментоядерный нейтрофил
Палочкоядерный нейтрофил
Палочкоядерный нейтрофил
 Эозинофил
Эозинофил
 Базофил
Базофил
 Лимфоцит
Лимфоцит
 Моноцит
Моноцит